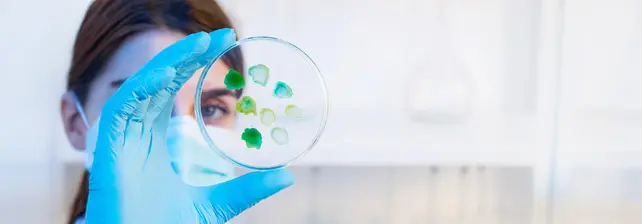
Ciencias Biológicas

Docentes
Bienvenidos a la Mesa de Ayuda para Docentes. Puede encontrar aquí datos de contacto, recursos de ayuda en diferentes formatos multimedia e información académica general.
SIU Guaraní | Consultas o Reclamos
Acceso al Sistema de Autogestión Académica

Enlace para acceder: http://autogestion.undec.edu.ar/
Por consultas o reclamos dirigirse a: autogestion@undec.edu.ar o a autogestionundec@gmail.com o puedes acercarte a Despacho de Alumnos en el Campus Los Sarmientos.
Secretaría de Gestión Académica: consultasga@undec.edu.ar
Cuenta UNdeC
Acceso a Teams (Microsoft)
Microsoft Teams es una plataforma que permite comunicarse por chat, videoconferencias o llamadas por audio y compartir documentos en la misma plataforma para trabajar de manera simultánea.
Por dudas o consultas dirigirse a la Dirección de Sistemas
Correos Electrónicos Importantes
Coordinación TICE-SIED
Dirección de Evaluación y Acreditación
Coordinación de Ingreso
Colegio Nacional Agrotécnico
Hades (Profesores)
Área de Idiomas
Secretaría de Gestión Académica
Pre Inscripción UNdeC
Autogestión Académica
Inscripción Finales
Títulos SGA
Fundación Hombre Libre
![]()
academica@fundacionhombrelibre.org
Información de Contacto
Directores de Carreras
Escuela de Ciencias Naturales
Directora: Dra. Susana Beatriz Popich
Escuela de Ciencias Humanas y de la Salud
Directora: Lic. Irene Soteras
Escuela de Ciencias Sociales
Director: Ab. Pablo Flaim

Tecnicatura Universitaria en Gestión de Emprendimientos Turísticos
Lic. Omar Palacios
opalacios@undec.edu.arEscuela de Ingeniería
Director: Ing. Enrique Nicolás Martínez

Tecnicatura Universitaria en Desarrollo de Aplicaciones Web
Ing. Enrique Nicolás Martínez
emartinez@undec.edu.arEscuela de Posgrado
Directora: Dra. Leonor Gimelfarb

Doctorado en Educación de Jóvenes y Adultos
Dra. María del Carmen Lorenzatti
mlorenzatti@undec.edu.ar
Diplomatura Superior de Instructor en Simulación Clínica
Esp. Lic. Romina Llerena
rllerena@undec.edu.ar
Acceso Bibliotecas Digitales

Biblioteca Digital e-Libro UNdeC
e-Libro es una plataforma digital académica en español, con más de 20 años de experiencia, 2500 bibliotecas académicas, 460 editoriales universitarias y más de 100.000 títulos que podrá consultar.
Para acceder al servicio de la biblioteca Digital de e-Libro como usuario de la UNdeC, debe ingresar al aula virtual 00-Biblioteca Digital E-libro UNdeC, en el campus virtual de la UNdeC.
Le recomendamos consultar los videos de ayuda publicados en el aula virtual de la Biblioteca.
Contacto: Ricardo Díaz (Biblioteca UNdeC): ridiaz@undec.edu.ar

Biblioteca Digital Bidi UNdeC
Bidi es una biblioteca digital con más de 1.000.000 de libros digitales, en alianza con 4000 sellos editoriales, que consolidan el catálogo más amplio y diverso del mercado.
Para acceder al servicio de la biblioteca Digital de Bidi como usuario de la UNdeC, deberán ingresar al link que vamos a compartir abajo y seguir las instrucciones del manual de usuario.
https://www.bidi.la/institutions
Contacto: Ricardo Díaz (Biblioteca UNdeC): ridiaz@undec.edu.ar
Capacitación
Cómo utilizar la Biblioteca Virtual UNdeC eLibro
Información
Librería Universitaria Argentina del CIN

La Librería Universitaria Argentina #LUA del #CIN ofrece en su web una variedad de títulos con descarga o lectura libre y gratuita. Libros clásicos de la literatura nacional, ensayos críticos, material técnico y novedades editoriales se presentan en un catálogo especial organizado en el contexto de la pandemia.
Enlace: librouniversitario.com.ar | https://lua.siu.edu.ar/categoria-producto/descarga-libre/
SIU Guaraní UNdeC
Manual de Ayuda | Autogestión Docente

El objetivo de este manual es brindar al docente un recurso que le permita usar correctamente el sistema académico de autogestión docente, principalmente en lo referido a carga de actas.
Acceso Institucional UNdeC
Herramientas de G Suite for Education para complementar el dictado de clases

Ingresar a servicio de Google MEET | Cuenta UNdeC
Debe ingresar al sitio web de Google MEET: https://meet.google.com/
En la pantalla de acceso debe ingresar con los siguientes datos:
Correo electrónico: su correo institucional UNdeC ( msanchez@undec.edu.ar )
Contraseña: MeetUndec* + los primeros 3 números del DNI del usuario, sin espacios (ejemplo: MeetUndec*317).
*Si tiene problemas para ingresar a su cuenta institucional de Google o desconoce sus datos de acceso, comuníquese a: coordinacion.tice.sied@undec.edu.ar
Podrá acceder, además, a los servicios de:
–Calendario (Google calendar): https://calendar.google.com/
Desde esta herramienta pueden programar/agendar con anticipación videoconferencias por MEET y enviar invitaciones y recordatorios.
–Almacenamiento y Documentos en línea (Google Drive): https://drive.google.com/
Pueden usar este espacio de almacenamiento del drive y documentos.
Documentos de Ayuda


















Evaluación y Seguimiento

- Ayuda sobre Herramientas de Evaluación y Seguimiento – Campus Virtual UNdeC – PDF
- Presentación sobre Evaluación Formativa (Parte 1) – Dra. María Alejandra Bowman – PDF
- Presentación sobre Evaluación Formativa (Parte 2) – Dra María Alejandra Bowman – PDF
- Ayuda Rápida sobre sección «Calificaciones». Consulta e informes de Calificaciones – PDF
En estos documentos encontrará ayuda conceptual y técnica sobre las herramientas que el campus virtual de la UNdeC dispone para generar instrumentos de evaluación y dar seguimiento a los estudiantes. El mismo incluye información sobre «Actividades», «Auto-evaluaciones», «Encuestas», «Calificaciones», «Foros de Debate» y herramientas de «Seguimiento».
Crear una Evaluación en el Campus Virtual UNdeC
Crear una Actividad en el Campus Virtual UNdeC
Evaluación Formativa (Parte 1) – Dra. María Alejandra Bowman
Evaluación Formativa (Parte 2) – Dra. María Alejandra Bowman
Seguimiento de Alumnos/Usuarios
Encuestas en Aulas Virtuales
Videos Tutoriales de Ayuda
Capacitación TICE| Aulas Virtuales | Parte I
Capacitación TICE | Aulas Virtuales | Parte II
Ayuda para Docentes | Campus Virtual UNdeC
Presentación del Aula Virtual | Animación
Recuperar Datos de Acceso al Campus Virtual
Si no recuerda sus datos personales de ingreso al campus virtual de la UNdeC, puede hacer clic en ¿Olvidaste tus datos?
Observará la ventana de Recordatorio de datos, en la cual debe completar los campos solicitados y se le enviará una notificación a su correo electrónico.
Cuando ingrese a su correo electrónico, tendrá en su bandeja de entrada un enlace con 8 horas de validez para restituir su clave de acceso.
Le sugerimos consultar el Video Tutorial.
Derechos y Deberes de los Autores
DERECHOS Y DEBERES DE LOS AUTORES DE MATERIALES VIRTUALES
Lic. Mónica E. Eines – II Workshop sobre Prácticas Educativas Abiertas (WPEA 2020).
Derechos de propiedad intelectual, Derechos de autor, Políticas de privacidad y Recursos Abiertos.
Capacitación Uso de Aulas Virtuales



Envíanos tu consulta a: coordinacion.tice.sied@undec.edu.ar
Herramientas Web para tus Clases en Línea

Google Meet

Microsoft Teams

Zoom

Cisco Webex

Jitsi Meet

Go To Meeting

Google Meet ha rediseñado su servicio de videoconferencias para que el mismo sea seguro, gratuito y esté disponible para todos los usuarios de GMAIL.
Enlace para acceder:
Solo es necesario ingresar a tu cuenta de Gmail y luego acceder al enlace de MEET.

Aplicación para Dispositivos Móviles
Podes descargar la aplicación desde la página: https://www.educativa.com/educativa-mobile-app/
Una vez que descargaste la aplicación debes ingresar la URL del campus de la UNdeC (https://campus.undec.edu.ar/) y tus datos de acceso para acceder.
Descarga para Android
Escaneá el código QR

Requerimientos
Móvil con Android 7.0 o superior.
Campus educativa al que te conectes en versión 9 o superior.
Descarga para iOS
Escaneá el código QR

Requerimientos
iOS 11.2 o posterior. Usando iPhone, iPad o iPod touch.
Que el Campus sea versión 9 o superior.